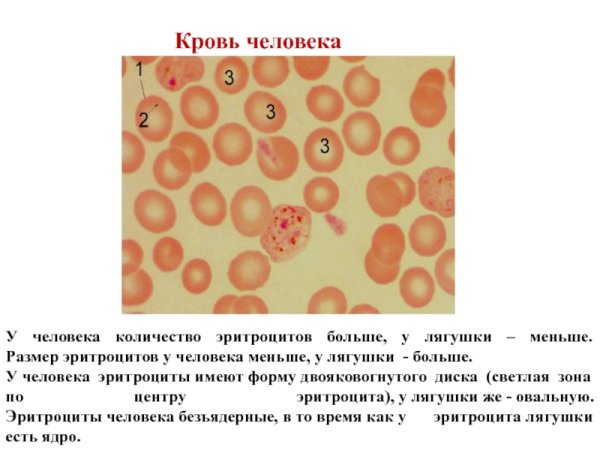
Строение клетки крови лягушки под микроскопом

Эритроциты – это красные кровяные клетки, выполняющие в организме ряд важных функций. В данном контексте мы говорим об эритроците лягушки рисунком, что означает изображение или рисунок, на котором изображен эритроцит, принадлежащий лягушке. Это может быть как иллюстрация для учебного материала, так и художественное изображение, созданное с помощью различных техник. Эритроциты лягушки рисунком могут представлять собой интересный объект для изучения структуры и функций клетки, а также служить декоративным элементом в различных проектах, связанных с биологией или искусством.
Строение клетки эритроцита лягушки
Строение эритроцитов лягушки рисунок
Строение эритроцитов лягушки рисунок
Строение эритроцита крови лягушки
Строение клетки крови лягушки под микроскопом
Эритроциты в крови лягушки под микроскопом
Форма клетки эритроцитов лягушки
Эритроциты и лейкоциты лягушки
Строение эритроцитов лягушки рисунок
Эритроциты в крови лягушки под микроскопом
Эритроциты человека и лягушки
Строение эритроцитов лягушки рисунок
Эритроциты и лейкоциты лягушки
Строение эритроцита крови лягушки
Строение эритроцитов лягушки рисунок
Строение эритроцита крови лягушки
Микроскопическое строение эритроцитов лягушки
Видовые различия эритроцитов
Строение клетки эритроцита лягушки
Мазок крови лягушки гистология
Микроскопическое строение крови
Клетка эритроцита лягушки под микроскопом
Мазок крови лягушки гистология
Эритроцит лягушки его форма и форма ядра
Строение эритроцитов лягушки рисунок
Строение эритроцита лягушки
Строение клетки крови лягушки под микроскопом
Лейкоциты в крови лягушки строение
Форма эритроцитов в крови лягушки
Строение клетки крови лягушки под микроскопом
Кровь лягушки и человека сравнение
Строение эритроцита крови лягушки
Лейкоциты в крови лягушки под микроскопом
Эритроциты лягушки под микроскопом
Лейкоциты в крови лягушки
Строение крови лягушки
Микропрепарат крови человека под микроскопом
Мазок крови гистология препарат
Микропрепарат крови лягушки
Строение эритроцитов земноводного
Микропрепарат кровь человека и кровь лягушки
Микропрепарат крови человека под микроскопом
Клетки крови лягушки под микроскопом
Строение клетки крови лягушки под микроскопом
Строение эритроцитов лягушки рисунок
Форма клетки эритроцитов человека и лягушки
Строение крови лягушки под микроскопом
Лейкоциты схема строения
Эритроцит лягушки рисунок (50 фото)

Grizly.club
Grizly.club